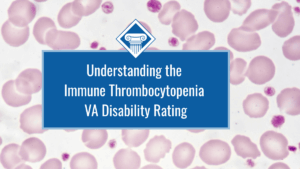
An image of platelets and other blood cells as viewed through a microscope. over the image is a blue box reading the article title" Understanding the Immune thrombocytopenia VA disability rating."

We share several opportunities for you to donate, volunteer, and otherwise support veterans during the holidays in 2025.
The VA Disability Rating for Eye Floaters Explained
Can you get a VA disability rating for eye floaters? This article explains.
Maine Veteran Benefits
We explain Maine disabled veteran benefits and how our VA disability appeal lawyers can help Maine veterans.
Kentucky Disabled Veteran Benefits
Woods & Woods helps veterans get the Kentucky veteran benefits they’re owed.
Honoring All Who Served on Veterans Day
You may be wondering how you can honor those who served on Veterans Day 2025. We share five ways you can celebrate this special occasion.
Eosinophilic Esophagitis (EoE) VA Rating
We explain what EoE is, how it may be connected to military service, and how you can get an eosinophilic esophagitis VA rating.
Connecticut Disabled Veteran Benefits
This article includes a list of the Connecticut 100% disabled veteran benefits, as well as benefits available to veterans with lower ratings.
2026 VA Disability Compensation Will Increase 2.8%
Veterans receiving VA disability compensation will see a 2.8% increase in their VA disability compensation payments for 2026.
Can You Get a VA Disability Rating for Thrombocytopenia?
We discuss what thrombocytopenia is, how it can be service connected, and how you can apply for a thrombocytopenia VA disability rating.
VA Rating for Vitamin Deficiency
This article explains if veterans can get a vitamin D deficiency VA rating and VA disability for other vitamin-related issues.
Idaho Veteran Benefits
Our Idaho VA disability appeal lawyers can help veterans get the VA compensation they deserve.
VA Disability for Agent Orange and Diabetes
The VA recognizes a connection between Agent Orange and diabetes. We explain how this can help you get the VA benefits you deserve.